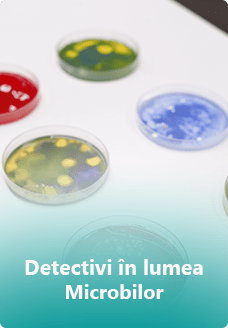
ceveideveni

Școala de vară
Detectivii în acțiune!
Școala de vară
Detectivii în acțiune!
Centrul de Limba Germana Fokus KIDS din Arad îi așteaptă pe cei mici cu vârsta cuprinsă între 2 și 10 ani la cea mai interactivă școala de vară în limba germană pentru copii în 2023: o abordare multi-senzorială, adaptată ultimelor descoperiri în materie de neuroștiințe cognitive, axată pe diferite activitați.
Aer liber
Jocuri
Cântece
Scenete
Multe alte surprize
Centrul de Limba Germana Fokus KIDS din Arad îi așteaptă pe cei mici cu vârsta cuprinsă între 2 și 10 ani la cea mai interactivă școala de vară în limba germană pentru copii în 2023: o abordare multi-senzorială, adaptată ultimelor descoperiri în materie de neuroștiințe cognitive, axata pe diferite activitați
Aer liber
Jocuri
Cântece
Scenete
Multe alte surprize
Ce spun părinții?
Ce spun părinții?
Vezi mai multe pareri pe pagina noastra de facebook https://www.facebook.com/pg/fokuskids.arad/reviews/
De ce Limba Germană la vârste fragede?
„Dovezile științifice în materie de neuroștiințe cognitive ne spun că învățarea limbii germane într-un mediu potrivit pentru studiul ei ajută la structurarea anumitor conexiuni neuronale, care îi dezoltă copilului nu doar capacitățile lingvistice, ci de asemenea inteligența logic-matematică, kinestezică, muzicală, inter- și intrapersonală.
Studiile privind plasticitatea creierului ne arată că legăturile neuronale slabe se pot reorganiza atunci când copiii invață lucruri noi sau memorează noi informații, cu condiția ca mediul și modul de lucru să fie adaptate proceselor neuronale de învățare.
Încălzirea prin exerciții fizice care să alunge din energia negativă neconsumată și oxigenarea potrivită pentru învățare a creierului, experiența multi-senzorială la care este expus copilul în procesul de învățare, recapitulările frecvente datorate principiului de predare prin suprapunere și repetare spațială, și jocurile de rol care îl transpun pe copil intr-o situație reală din viață unde este nevoit să folosească lucrurile învățate fac din metoda FOKUS una de succes”, susține fondatorul Centrului de Limba Germana FOKUS, specialist în tehnici de învățare accelerată, Andrei Farca.
Copiii sunt moștenirea noastră cea mai mare, de aceea nici un efort nu este prea mare pentru a adauga valoare ființei lor. Cursurile Fokus KIDS au loc pe tot parcursul anului școlar iar Școala de Vară reprezintă pentru copiii dv. o ocazie inedită de a învăța lucruri noi în limba germană iar pentru personalul nostru o provocare de a face din aceasta experiență una de neuitat pentru cei mici.
Școala de Vară în Limba Germană – Fokus KIDS
19 iunie – 8 septembrie | Strada Ghioceilor, nr. 61, Arad
În fiecare săptămână vom aborda un subiect nou, pe care îl parcurgem și îl îmbogățim în fiecare zi cu vocabular nou pe care îl punem în practică prin activități interactive, jocuri, cântece, scenete, teatru de păpuși, povești și activități practice!
Școala de Vară în Limba Germană Fokus KIDS
19 iunie – 8 septembrie | Strada Ghioceilor Nr. 61, Arad
În fiecare săptămână vom aborda un subiect nou, pe care îl parcurgem și îl îmbogățim în fiecare zi cu vocabular nou pe care îl punem în practică prin activități interactive, jocuri, cântece, scenete, teatru de păpuși, povești și activități practice!
Frații beneficiază de DISCOUNT
Pentru informatii suplimentare vă așteptăm cu drag la sediu nostru sau ne puteți contacta telefonic la nr. 0755.100.007 sau 0756.201.639.